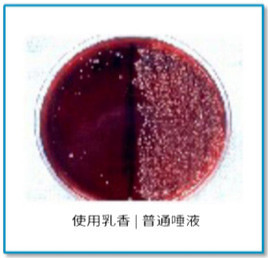

商品详情


说真的,口臭比狐臭、脚臭更让人窒息,一张嘴就能闻到,想瞒都瞒不住。
像我,平时刷牙很勤快,但嘴巴老飘着一股异味。

诶?为什么很多人不知不觉就有了口臭,还怎么都去不掉?
这还得从口臭的原因找起。
引发口臭的元凶可能是一个特殊的东西——HP。
食物偏辛辣油腻,喝酒,熬夜……都可能让它趁虚而入,加重口臭。

这臭味可是从肚子里散发出来的,所以拼命刷牙不能解决问题。
更好的方式是吃进去,抑制它。
我最近就一直在吃 荷兰bluem的护理爆珠 ,它采用了非常珍贵的乳香,专门对抗HP。

不得不说,清新口气一级棒,还能提神解困、护理口腔健康。
害!之所以选它,还不是因为我扒了一下发现它的创始人大有来头。

▲创始人是欧洲非常有名的博士
作为专业口腔护理品牌,它家的东西是专家御用的产品,吃进去的东西,还得找这种信得过的。
我第一次吃就被惊到了,含在嘴里秒爆汁,口腔中的异味一扫而空,散发着一股薄荷清香。

我先前去洗牙口臭也没缓解多少,吃了它反到好了一些,嘴巴不干不苦,清清爽爽。
办公室那个口臭得人神共愤的同事,吃了爆珠口气清新了不少。

你还别不信,咱用数据说话,看,bluem的抑菌除臭率超高。

还拿到了德国健康营养食品协会认证、荷兰消费者选择品牌金奖。

(左:德国健康营养食品协会认证;右:荷兰消费者选择品牌金奖)
在国外一些大型超市、商场逛街时也能看到它的身影,火到不行。

blum实力爆表,连湖南卫视「我是大美人」节目也强烈推荐。

身边很多被口臭困扰的朋友,吃后也缓解了很多,现在天天带着它,需要时就吃上几颗。


为了去口臭,我试过清口糖、漱口水、牙膏,但有效除口臭的,bulem是为数不多的一个。
bluem口腔爆珠之所以效果这么好,就在于它选用了珍贵的爱琴海乳香油。

说起乳香油,你可能觉得陌生,它是在黄连木中提取的树脂,这好东西还被称为“液体黄金”呢。

专家巴巴拉博士就说过,乳香油是非常好的产品。

不过这乳香好是好,但种植难度高,得靠人工种植,产量稀少。
一盒bluem的爆珠中含有9%的乳香油,已经是非常非常高的含量了。
不信你去搜一下,市面上很少有含量这么高的乳香油产品。

重点是,乳香油是HP的天敌。
我可不是瞎说,已经有很多权威报告证实了它的厉害。
新英格兰期刊也研究过,它的的确确可以抑制口臭祸害HP。

日本静冈县立大学的学术报告也证实了,乳香油能让HP无处遁形。

日本汉方研究所做了个实验,在左边的唾液中添加乳香油,HP明显少了很多;
右边的唾液没有加乳香油,HP超级多。
如此难得的乳香,平时来一粒,缓解口臭,长期坚持,还能养护口腔健康。
最近戴着口罩,闻着自己的口气贼难受,吃了它异味没有了。

口腔内还萦绕乳香的香草气味,仿佛还带着阳光的明媚感。


乳香不仅珍贵,保存起来也特别困难。
一般的乳香产品,会因为失去活性氧而没了功效。
怪不得我之前吃了其他品牌的乳香糖,没啥效果。
但这对bluem来说并不是难事。

bluem跟专业的日本大品牌三生合作,一起攻克了这个瓶颈。
严选了数百种材料,历经千百次实验,最终选用昆布,开发了无缝胶囊技术。

这技术,能阻抑HP在体内作乱,从内到外清新口气。
不仅如此,专家们还研发出了独特的超强技术,活性氧。
当爆珠一爆破,释放出的活性氧,可以快速清新口气。

俩黑科技一结合,能牢牢锁住乳香的活性,让它更好地发挥作用。
同事也说,吃麻辣锅加上熬夜写稿,嘴巴臭烘烘,吃其他爆珠,一张嘴还是一股怪味。
吃了bluem,嘴里清新到不行,浓郁的火锅味也被击退了。

她还说,专家不愧是专家,这爆珠的除口臭效果能甩别人几条街了。


我们平时吃口香糖、喷口气清新剂,当下确实能清新口腔,过会儿感觉气味又上来了。
但bluem吃完后,清新度超持久久久久。
原来除了乳香,它里头还加了植物薄荷精华。

薄荷就像一个卫士,上阵杀敌,保护口腔。
就算嘴里的凉感已经消失,嘴巴里面还是香香的,每一口呼吸都带着薄荷味。
而且乳香+薄荷油,具有很强的镇静作用,可以去除异味。

重点是,市面上的清口糖为了去口臭,加了很多添加剂,味道过于刺激。
这款爆珠,无激素、无糖,孕妇和哺乳期的姐妹都能吃。

聪明的我还发现它不止能去口臭,还有很多隐藏功能。
抽烟后吃 | 男同事爱抽烟,但老婆闻不得烟味。自从有了这个法宝,抽完烟来一颗,烟味去无踪。
鼻子不通气来一颗 | 我之前鼻塞的时候难受到不行,突发奇想捏碎闻一闻,很快鼻子就通气了,呼吸顺畅。
提神醒脑 | 开车时昏昏欲睡,珠子在嘴里爆炸的一瞬间,嘶~清醒了~再大的困意都能赶跑。

像我上班,侄女上网课,就爱备着它,下午含一颗,精神百倍。


和我之前吃过的清口糖不同,它是QQ弹弹的半透明质地,一捏爆汁。

放进口腔中,汁水爆开,融入一股清凉感,就像炎热的夏天被海浪冲击般,酷劲爽。

▲看,这汁水就是乳香油和薄荷油
不管之前吃了大蒜韭菜,还是顽固性口臭,嘴巴里只剩香气了。
包装也深得我心,天空白纯净蓝配色,很显高级有气质。

我以前也会带着口香糖出门,但是糖盒体积大,走起路来“哗哗”响,蛮尴尬。
这款爆珠糖,跟口红差不多大,装在兜里不会响,完全不会成为负担。

推拉式的外壳设计+小卡口,吃一颗取一颗,不会全部散落出来,干净卫生。

每天1块多,方便随时清洁口腔,让你的每一口呼吸,都带着清新薄荷味。


- 悦书简
- 扫描二维码,访问我们的微信店铺















